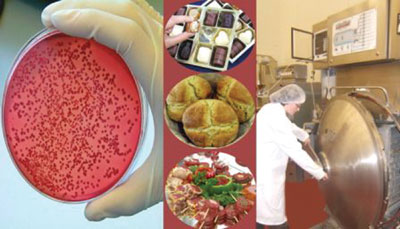

| 2006 |

|
YEAR BOOK |
Teagasc, Ashtown Food Research Centre
|
Teagasc innovating for the Irish food industry
|
This initiative is underpinned by the strong science and technology generated within this internationally reputed food research centre. The staff of highly skilled food technologists, microbiologists, chemists, technicians, trainers, consultants and market specialists at Ashtown Food Research Centre work alongside the innovation team to provide focused technology transfer and support to food businesses. The Innovation Unit has established strong linkages with agencies such as Enterprise Ireland, Bord Bia and Bord Iascaigh Mhara who can help support development work, and the staff can assist in funding applications as well as establishing collaborative partnerships with relevant researchers.
The facilities include a purpose built product development plant and fully licensed meat development unit containing state of the art equipment which can be used by companies wishing to conduct pilot scale processing. Two incubation units are also available for hire to companies or entrepreneurs who wish to develop innovative products but do not have the space or facilities to do so. A fully equipped test kitchen provides the ideal venue for the preparation and presentation of products to potential buyers. Support services include product innovation and development, sensory analysis, shelf-life testing, consultancy and training, ingredient and equipment sourcing.
Contact: Ciara Mc Donagh,
Ashtown Food Research Centre,
Teagasc, Ashtown, Dublin 15,
Tel: 01 8059500, Fax: 01 8059550.
E-mail: [email protected] .